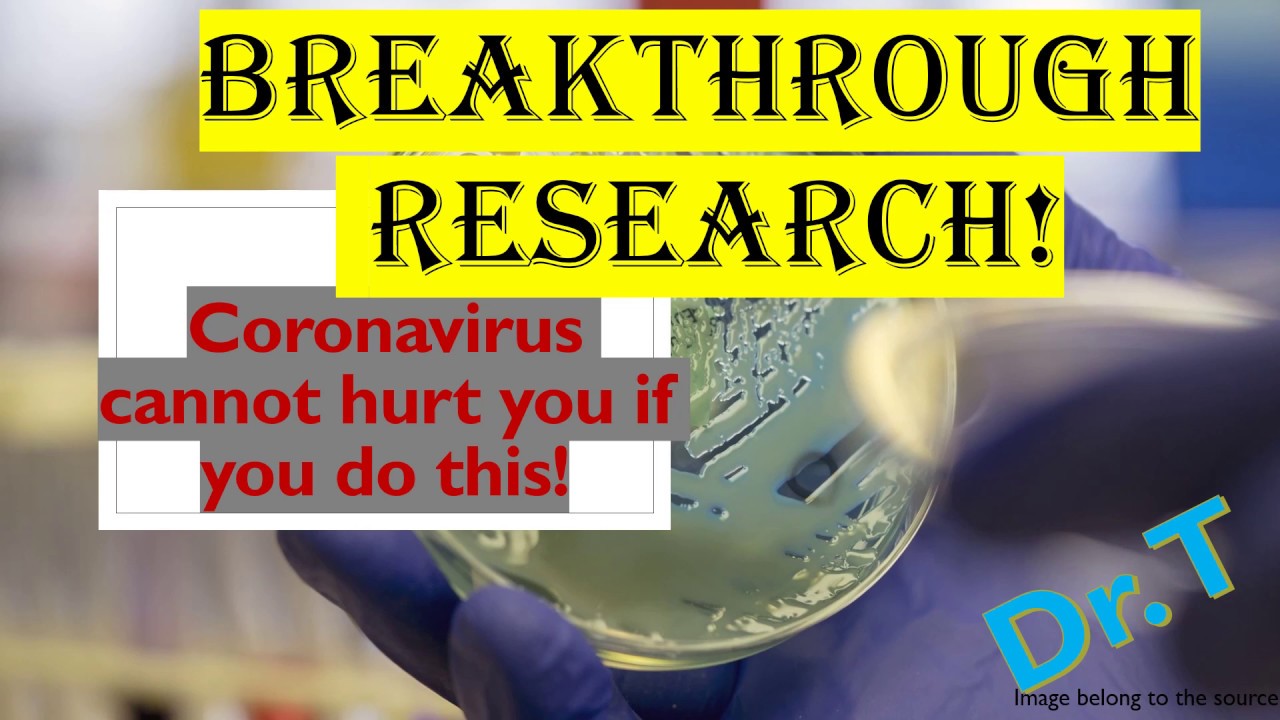

#Coronavirus #Onestop Academy #Dr.T #COVID19
As the coronavirus pandemic accelerates, doctors are getting real-time experience treating patients and discovering more and more about how the symptoms of COVID-19 develop. They can include headaches, coughing and no sense of smell.
May 9, 2020




